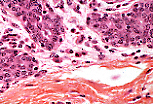

|
对于缺乏经验的观察者而言,在组织学切片上观察血管有时会遇到一些问题。实际上,在检查厚度为5微米的切片时,必须始终考虑到切片的切入角度问题(斜切、切线切),同时也要考虑到标本制备过程中可能出现的、会影响血管形态的技术性问题。
|

|
在切片展平过程中,往往难以消除所有的褶皱。
若在大血管管壁处观察到此类褶皱,切勿将其与血管滋养管相混淆。
|

|
在切片机切片过程中,血液常会产生人为伪影,例如出现“啃切”现象(组织被机械性啃咬破坏)。
|
|
在固定和脱水过程中,组织内部有时会产生收缩。由此,胶原纤维束之间可能会出现人为的间隙。
这些间隙中常常会观察到染料沉积。切勿将这些人为伪影误认为是血管结构(例如:毛细淋巴管),也不要将染料沉积误认为是淋巴液或血液。
|

|
在某些血管(此处为微静脉)的管腔内,红细胞数量有时极为庞大,它们会堆积并变形,形成蜂窝状的图像,切勿将其与内皮细胞骨架的切线切片相混淆。
|

|
根据固定方式的不同,红细胞可能不会被染料着色,从而呈现出“空影”样的外观。
|